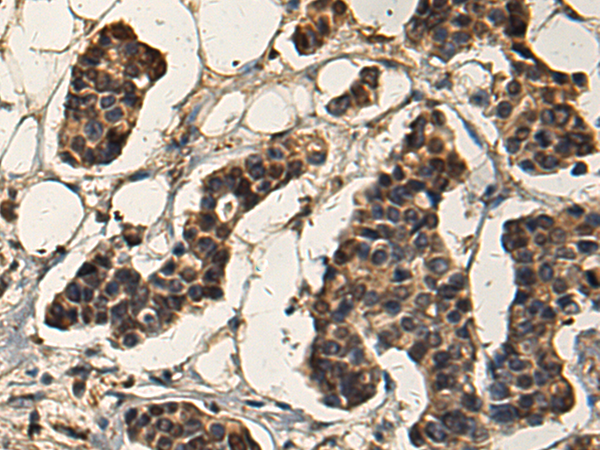
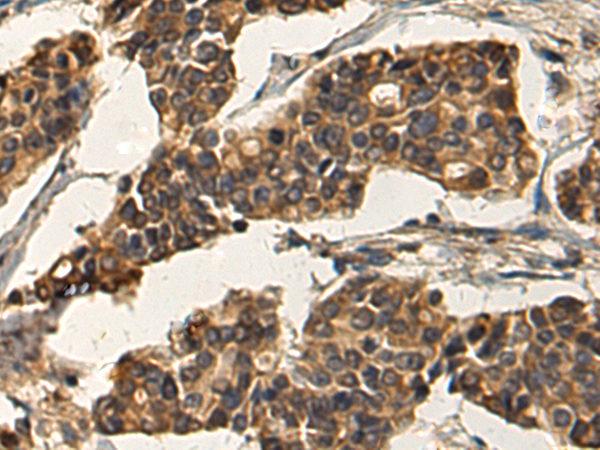

-
分类: 科研抗体货号: P10442别名: IF; GIF; INF; IFMH; TCN3应用: IHC反应种属: Human, Mouse, Rat
-
分类: 科研抗体货号: P10423别名: SAV; WW45; WWP4应用: WB,IHC反应种属: Human, Mouse, Rat
-
分类: 科研抗体货号: P10407别名: TEF3; RTEF1; TEF-3; EFTR-2; TEFR-1; TCF13L1; hRTEF-1B应用: WB反应种属: Human, Mouse
-
分类: 科研抗体货号: P10440别名: STK32; STKG6; YANK2; HSA250839应用: WB,IHC反应种属: Human, Mouse
-
分类: 科研抗体货号: P10422别名: 3PK; MK-3; MDPT3; MAPKAP3; MAPKAP-K3; MAPKAPK-3应用: WB,IHC反应种属: Human, Mouse, Rat
-
分类: 科研抗体货号: P10406别名: TMOD; ETMOD; D9S57E应用: WB,IHC反应种属: Human, Mouse, Rat
-
分类: 科研抗体货号: P10439别名: DEP.6; DEPDC6应用: WB,IHC反应种属: Human, Mouse
-
分类: 科研抗体货号: P10421别名: MST161; SLRR2A; MSTP161应用: WB,IHC反应种属: Human, Mouse, Rat
-
分类: 科研抗体货号: P10405别名: FCRL; FCRX; FREB; FCRL1; FCRLX; FCRLb; FCRLd; FCRLe; FCRLM1; FCRLc1; FCRLc2应用: WB,IHC反应种属: Human
-
分类: 科研抗体货号: P10438别名: AP2REP; AP-2rep; HSPC122应用: IHC反应种属: Human, Mouse

鄂公网安备42018502007531号
鄂公网安备42018502007531号

